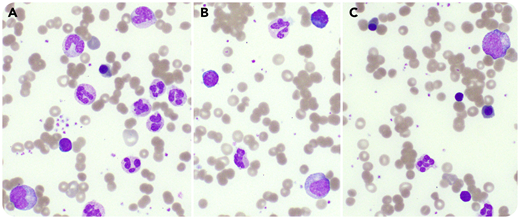
A 7-year-old girl with severe acute respiratory syndrome coronavirus 2 (SARS-CoV-2) exposure presented with 4 days of fever, nausea, vomiting, diarrhea, and dark urine. At presentation, she was febrile (39.7°C), tachycardic, and tachypneic with normal blood pressure. Conjunctivitis, oropharyngeal erythema, cracked lips, and a distended abdomen were noted. Polymerase chain reaction testing for SARS-CoV-2 was positive. Laboratory testing showed elevated inflammatory markers, liver enzymes, and D-dimer. Two days after admission, her complete blood count revealed the following: white blood cell count, 63.1 × 109/L; hemoglobin, 6.9 g/dL (with a normal mean corpuscular volume); and platelets, 370 × 109/L. A peripheral blood smear showed 55% neutrophils, 9% bands, 8% metamyelocytes, 5% myelocytes, 13% monocytes, and 10% lymphocytes (panel A; original magnification ×600, Wright-Giemsa stain). There were also plasmacytoid lymphocytes (panel B; original magnification ×600, Wright-Giemsa stain), anisocytosis, and 7% nucleated red blood cells (panel C; original magnification ×600, Wright-Giemsa stain). The patient received 1 mg/kg prednisone and 81 mg of aspirin daily and changes resolved in 4 days.

A 7-year-old girl with severe acute respiratory syndrome coronavirus 2 (SARS-CoV-2) exposure presented with 4 days of fever, nausea, vomiting, diarrhea, and dark urine. At presentation, she was febrile (39.7°C), tachycardic, and tachypneic with normal blood pressure. Conjunctivitis, oropharyngeal erythema, cracked lips, and a distended abdomen were noted. Polymerase chain reaction testing for SARS-CoV-2 was positive. Laboratory testing showed elevated inflammatory markers, liver enzymes, and D-dimer. Two days after admission, her complete blood count revealed the following: white blood cell count, 63.1 × 109/L; hemoglobin, 6.9 g/dL (with a normal mean corpuscular volume); and platelets, 370 × 109/L. A peripheral blood smear showed 55% neutrophils, 9% bands, 8% metamyelocytes, 5% myelocytes, 13% monocytes, and 10% lymphocytes (panel A; original magnification ×600, Wright-Giemsa stain). There were also plasmacytoid lymphocytes (panel B; original magnification ×600, Wright-Giemsa stain), anisocytosis, and 7% nucleated red blood cells (panel C; original magnification ×600, Wright-Giemsa stain). The patient received 1 mg/kg prednisone and 81 mg of aspirin daily and changes resolved in 4 days.
Multisystem inflammatory syndrome in children (MIS-C) is a rare, newly reported manifestation of infection with SARS-CoV-2 that shares features with Kawasaki disease. Although plasmacytoid lymphocytes are frequently seen in critically ill COVID-19+ children, leukoerythroblastosis is unusual (institutional experience). One case report describes this finding in a COVID-19+ adult with respiratory failure, but little is known about the hematologic manifestations of MIS-C (A. Mitra, D. M. Dwyre, M. Schivo, et al, Am J Hematol. doi:10.1002/ajh.25793). Interestingly, leukoerythroblastosis can occur in children with Kawasaki disease. These findings help broaden awareness of the spectrum of SARS-CoV-2 infection in children.
A 7-year-old girl with severe acute respiratory syndrome coronavirus 2 (SARS-CoV-2) exposure presented with 4 days of fever, nausea, vomiting, diarrhea, and dark urine. At presentation, she was febrile (39.7°C), tachycardic, and tachypneic with normal blood pressure. Conjunctivitis, oropharyngeal erythema, cracked lips, and a distended abdomen were noted. Polymerase chain reaction testing for SARS-CoV-2 was positive. Laboratory testing showed elevated inflammatory markers, liver enzymes, and D-dimer. Two days after admission, her complete blood count revealed the following: white blood cell count, 63.1 × 109/L; hemoglobin, 6.9 g/dL (with a normal mean corpuscular volume); and platelets, 370 × 109/L. A peripheral blood smear showed 55% neutrophils, 9% bands, 8% metamyelocytes, 5% myelocytes, 13% monocytes, and 10% lymphocytes (panel A; original magnification ×600, Wright-Giemsa stain). There were also plasmacytoid lymphocytes (panel B; original magnification ×600, Wright-Giemsa stain), anisocytosis, and 7% nucleated red blood cells (panel C; original magnification ×600, Wright-Giemsa stain). The patient received 1 mg/kg prednisone and 81 mg of aspirin daily and changes resolved in 4 days.
Multisystem inflammatory syndrome in children (MIS-C) is a rare, newly reported manifestation of infection with SARS-CoV-2 that shares features with Kawasaki disease. Although plasmacytoid lymphocytes are frequently seen in critically ill COVID-19+ children, leukoerythroblastosis is unusual (institutional experience). One case report describes this finding in a COVID-19+ adult with respiratory failure, but little is known about the hematologic manifestations of MIS-C (A. Mitra, D. M. Dwyre, M. Schivo, et al, Am J Hematol. doi:10.1002/ajh.25793). Interestingly, leukoerythroblastosis can occur in children with Kawasaki disease. These findings help broaden awareness of the spectrum of SARS-CoV-2 infection in children.
For additional images, visit the ASH Image Bank, a reference and teaching tool that is continually updated with new atlas and case study images. For more information, visit http://imagebank.hematology.org.
This feature is available to Subscribers Only
Sign In or Create an Account Close Modal